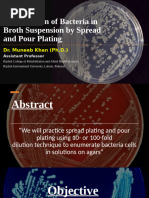

0% found this document useful (0 votes)
36 views23 pagesMicrobial Count
The document outlines various methods for determining microbial counts, including the pour plate method, most probable number (MPN), and direct microscopic count. It details the procedures for the pour plate method, including sample preparation, incubation, and calculation of colony-forming units (CFU). Additionally, it provides instructions for estimating microbial counts in water samples using sterile materials and specific incubation conditions.
Uploaded by
yasserhanna.comCopyright
© © All Rights Reserved
We take content rights seriously. If you suspect this is your content, claim it here.
Available Formats
Download as PDF, TXT or read online on Scribd
0% found this document useful (0 votes)
36 views23 pagesMicrobial Count
The document outlines various methods for determining microbial counts, including the pour plate method, most probable number (MPN), and direct microscopic count. It details the procedures for the pour plate method, including sample preparation, incubation, and calculation of colony-forming units (CFU). Additionally, it provides instructions for estimating microbial counts in water samples using sterile materials and specific incubation conditions.
Uploaded by
yasserhanna.comCopyright
© © All Rights Reserved
We take content rights seriously. If you suspect this is your content, claim it here.
Available Formats
Download as PDF, TXT or read online on Scribd